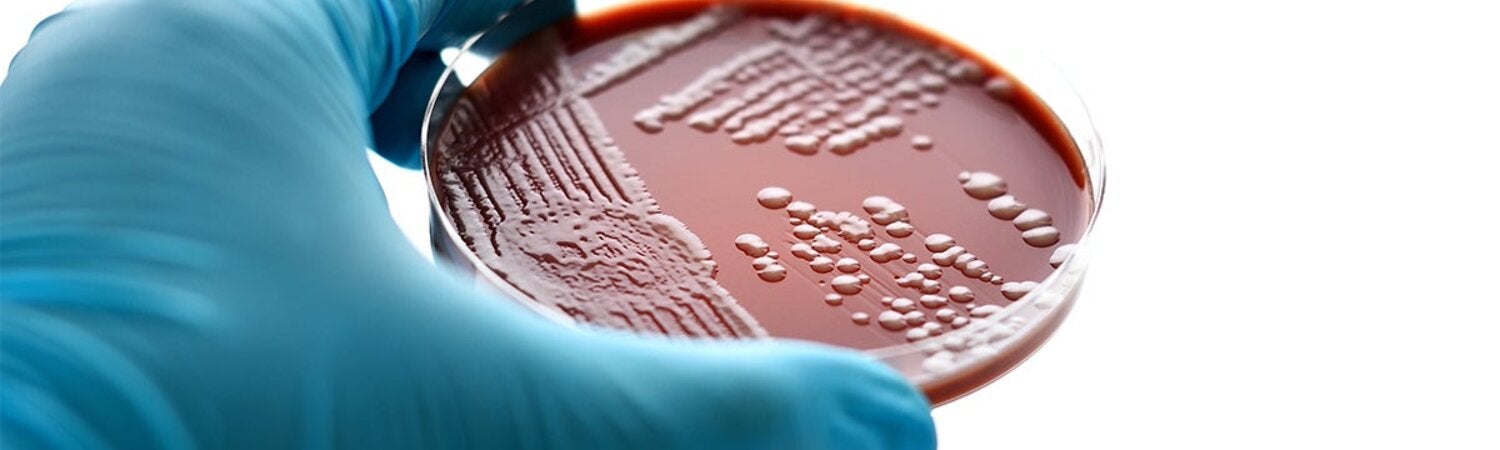
lab gonorrhea petri dish

Gonorrhea, caused by Neisseria gonorrhoeae, is the second most common bacterial STI and results in substantial morbidity and economic cost worldwide. Gonorrhea is spread by having unprotected vaginal, anal, or oral sex with someone who has gonorrhea, or from mother-to-child during childbirth. Correct and consistent use of condoms significantly decreases the risk of sexual transmission.
Gonorrhea is often asymptomatic in women. If untreated, gonorrhea infection may lead to serious complications.
Of all the STIs, gonorrhea is the most antibiotic-resistant. Increased resistance to most antibiotics used to treat gonococcal infections has been reported worldwide, raising concerns about the eventual development of untreatable gonococcal infections with serious sexual and reproductive health consequences.
To the extent possible, countries should update their national guidelines for the treatment of gonococcal infection based on recent antimicrobial resistance (AMR) surveillance. If local ARM surveillance in not yet functional, PAHO urges countries to adopt the latest WHO treatment guidelines for N. gonorrhoeae.
- According to the Latin American AMR Surveillance Network (ReLAVRA), ciprofloxacin resistance has steadily grown, with isolates increasing from 35% in 2009 to 62% in 2015. Moreover, reduced sensitivity to broad spectrum cephalosporins and macrolides is beginning to emerge in Latin America and the Caribbean (LAC).
- While there are documented increases in gonococcal resistance to antimicrobial drugs, only 36% of the countries in the Americas systematically monitor this resistance to support treatment decisions
- In 2017, only 8% of the countries in LAC reported the use of ceftriaxone plus azithromycin, as recommended in the WHO treatment guidelines.
Gonorrhea is the second most common sexually transmitted infection (STI) caused by bacteria in the world. In women is mostly asymptomatic and it can cause serious health problems if not treated. Of all the STIs, gonorrhea is the most resistant to antibiotics. Because of widespread resistance, older and cheaper antibiotics have lost their effectiveness in treatment of the infection, and gonorrhea infection may become untreatable.
You can get gonorrhea by having unprotected vaginal, anal, or oral sex with someone who has gonorrhea. You can still get gonorrhea even if you had it in the past and got treatment for it. It can also be transmitted from mother-to-child during childbirth.
Correct and consistent use of condoms significantly decreases the risk of infection during anal, vaginal or oral sexual contact. For all neonates, the WHO STI guideline recommends topical ocular prophylaxis for the prevention of gonococcal and chlamydial ophthalmia neonatorum (eye infection).
Many people with gonorrhea do not show any symptoms, with less than half of infected women expressing non-specific symptoms. If you do have symptoms, they can appear in different forms. Women might notice irregular vaginal discharge, pain when urinating, discomfort in the lower part of the stomach, or bleeding from the vagina after sex or between periods. Men might notice pain when urinating, pus-like discharge from the penis, or pain or swelling in one testicle.
In both men and women rectal infection often do not cause symptoms, but in some cases, you may have rectal and anal pain or discharge. Throat infections can also occur and, in most cases, are asymptomatic, but mild sore throat or inflammation in the back of the throat could happen.
Gonorrhea is often asymptomatic in women, and the lack of discernible symptoms results in unrecognized and untreated infections. If left untreated, gonorrhea usually resolves naturally, but can also cause serious health problems. For women this could include pelvic inflammatory disease (PID), which can lead to ectopic pregnancy (pregnancy outside the womb) and inability to have a baby. In men, health problems could include epididymitis (inflammation of the tube that stores and carries sperm at the back of the testicle), urethral stricture (narrowing of the urine canal) and inability to have a baby. The risk of complications increases with repeated infection.
Infants of mothers with gonococcal infection can be infected at delivery, resulting in neonatal conjunctivitis (eye infection) manifesting as purulent ocular discharge and swollen eyelids. Untreated conjunctivitis may lead to scarring and blindness.
Diagnosis is made in a laboratory using different samples, including urine, and vulvovaginal, cervical, and urethral swabs. However, since laboratory diagnostic tests are not available in many countries, a qualified care provider may treat you based on the presence of symptoms such as vaginal and urethral discharge.
There have been major developments in the diagnosis of gonorrhea including using rapid molecular diagnostic tests, some combined with tests for chlamydia.
The WHO guidelines for the treatment of gonorrhea recommends that local antimicrobial resistance (AMR) data should guide national treatment guidelines. In settings where local AMR data are not available, WHO suggests dual therapy over single therapy for people with genital or anorectal gonorrhea (conditional recommendation, low quality evidence)
Dual therapy (one of the following):
- ceftriaxone 250 mg intramuscular (IM) as a single dose PLUS azithromycin 1 g orally as a single dose.
- cefixime 400 mg orally as a single dose PLUS azithromycin 1 g orally as a single dose.
With the right treatment, gonorrhea infection can be cured completely. However, it is becoming harder to treat some forms of gonorrhea infection, because the bacteria have developed resistance to nearly all the antibiotics used for its treatment.
However, since laboratory diagnostic tests are not available in many countries, a qualified care provider may treat you based on the presence of symptoms such as vaginal and urethral discharge.
Antimicrobial resistance happens when microorganisms (such as bacteria, fungi, viruses, and parasites) change when they are exposed to antimicrobial drugs (such as antibiotics, antifungals, antivirals, antimalarials, and anthelmintics). Microorganisms that develop antimicrobial resistance are sometimes referred to as "superbugs". As a result, the medicines become ineffective and infections persist in the body, increasing the risk of spread to others. Antimicrobial resistance is an increasingly serious threat to global public health that requires action across all government sectors and society.
- The global response to STI is currently guided by the Global health sector strategy on sexually transmitted infections, 2016 - 2021
- The Plan of Action for the Prevention and Control of HIV and Sexually Transmitted Infections (2016-2021) provides lines of action for Member States and PAHO to enhance and expand the prevention and control of HIV and STIs in the Americas
- The Plan of Action for Antimicrobial Resistance (2015-2020) provides committed and coordinated support to the countries’ efforts to contain antimicrobial resistance
- PAHO’s Latin American Surveillance Network of Antimicrobial Resistance (ReLAVRA for its Spanish Acronym) aims at reporting the magnitude and trends of antimicrobial resistance in the Region, using routine data of microbiology laboratories
- WHO’s Gonococcal Antimicrobial Surveillance Programme (GASP) tackles this public health problem through a worldwide laboratory network that is coordinated by regional coordinating centers, including ReLAVRA
- In 2016, WHO developed the Guidelines for the Treatment of Neisseria gonorrhoeae providing updated recommendations for the treatment of gonorrhea based on the most recent evidence
- WHO and PAHO released, in 2018, a “Standard protocol to assess prevalence of gonorrhoea and chlamydia among pregnant women in antenatal care clinics” to support national and regional estimates of the burden of N. gonorrhoeae infections.
- And in 2020, PAHO launched a new guidance to support countries implementing and/or improving their antimicrobial resistance (AMR) surveillance of N. gonorrhoeae, integrated with the surveillance of gonorrhea infections
- PAHO facilitates and foster technical cooperation among countries, key partners and civil society organizations and provides direct technical assistance to countries to support the achievement of the elimination of priority sexually transmitted infections (STIs) as a public health problem by 2030
Gonorrhea in the Americas | |
| Co-infection with Chlamydia trachomatis is detected in 10–40% of people with gonorrhea worldwide | |
| WHO estimates that in 2012, 78 million new cases occurred among adolescents and adults aged 15–49 years worldwide with a global incidence rate of 19/1000 females and 24/1000 males. The estimated 27 million prevalent cases of gonorrhea in 2012 translates to a global prevalence of gonorrhea of 0.8% among females and 0.6% among males aged 15–49 years | |